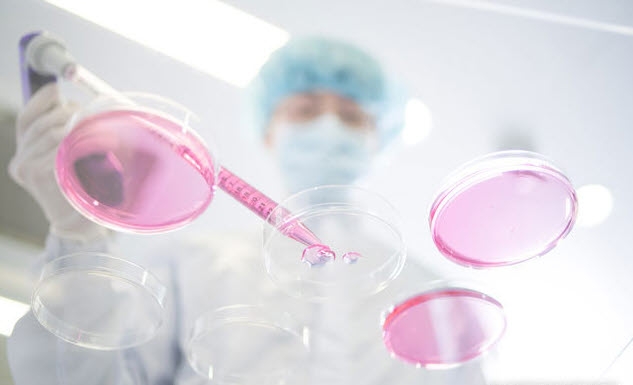

FDA, 최근 알츠하이머 치료제 레켐비 가속 승인
경쟁 약물로 대두된 '도나네맙' 가속 승인은 거절
31일 한국바이오협회 바이오경제연구센터 이슈 브리핑에 따르면, 레켐비는 알츠하이머 치료제 시장에서 초기 시장 점유율 확보에 쉬울 것으로 보인다.
앞서 미국 식품의약국(FDA)은 지난 6일 미국 바이오젠과 일본 에자이가 공동 개발한 레켐비를 가속 승인했다.
치료 수요가 높으나 마땅한 치료제가 없을 경우 가속 승인을 하게 된다.
FDA는 앞서 논란이 됐던 알츠하이머 치료제 ’아두헬름‘(성분명 아두카두맙)에 이어 레켐비를 두 번째 알츠하이머 치료제로 승인했다.
또 레켐비는 인지 기능 저하를 늦추는 효과가 있는 첫 번째 알츠하이머 치료제가 됐다.
레켐비는 대규모 환자를 대상으로 하는 임상 3상 데이터 대신 상대적으로 규모가 적은 환자를 대상으로 안전성과 효과를 확인하는 임상 2상 데이터를 기반으로 승인됐다.
다만 바이오젠·에자이의 지난해 11월 발표에 따르면, 레켐비는 증상이 있는 알츠하이머병 초기단계(경도인지장애 또는 경도치매) 환자 1795명을 대상으로 진행된 임상 3상 결과에서 임상치매평가척도(CDR-SB) 점수를 측정한 결과, 치료 18개월 동안 인지 및 기능 저하를 27% 지연시키는데 성공했다.
또 뇌부종·뇌출혈 등을 뜻하는 아밀로이드 관련 영상 이상(ARIA) 발생률이 약 10%로, 아두헬름 대비 40% 개선된 것으로 알려졌다.
레켐비 역시 임상과정에서 3명의 환자가 사망해 안전성에 대한 우려도 있다.
미국 공공의료보험기관(CMS)은 최근 자료를 배포하고 레켐비가 (FDA)정식 승인을 받기 전까지는 보험 적용 범위를 확대할 수 없다고 언급한 바 있다.
그러나 레켐비는 초기 시장 점유율 확대에 유리할 것으로 보인다. 아두헬름은 효과 논란에 휩싸인 상태다. 경쟁 약물의 경우 최근 FDA가 가속 승인을 거절했기 때문이다.
미국 정부 임상시험등록사이트 ’크리니컬트라이얼즈‘(clinicaltrials.gov)에 따르면, 작년 기준 알츠하이머병 치료제 개발에 따른 임상시험은 총 172개로 나타났다.
이 중 임상 1상이 31개, 2상 94개, 3상 47개다.
바이오경제연구센터 박봉현 책임연구원은 “임상 3상에 있는 물질들의 가속 승인 신청이 잇따를 것으로 예상되나, 임상 3상 신약후보물질 중 가장 승인에 근접해 있는 것은 2021년 가속 승인받은 아두헬름 이외에 '도나네맙'(성분명)과 레켐비였다”고 밝혔다.
그러면서“그러나 지난 19일 FDA가 일라이 릴리가 신청한 알츠하이머병 신약 도나네맙의 가속 승인을 거절하면서 레카네맙의 초기 시장 확보가 더 유리해질 것으로 전망된다”고 분석했다.
news@beyondpost.co.kr




















